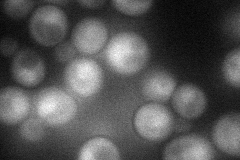
YOL117W

View description
Subunit of the COP9 signalosome (CSN) complex that cleaves the ubiquitin-like protein Nedd8 from SCF ubiquitin ligases; plays a role in the mating pheromone response
Localization:
Intensity:
Fold change:
Significance:
-
C’ GFP library in SD

below threshold16.58 -
N' NOP1pr-GFP in SD
cytosol,nucleus40.928 -
N' TEF2pr-mCherry in SD

cytosol,nucleus9.58434 -
N' NATIVEpr-GFP in SD

below threshold19.7398 -
N' TEF2pr-VC and Cyto-VN in SD

below threshold23.9897 -
C’ GFP library in SD+DTT

cytosol15.520.93No -
C’ GFP library in SD+H2O2

cytosol17.951.08No -
C’ GFP library in Starvation Media

cytosol16.540.99No -
C’ GFP library on the background of Pup2-DaMP

below threshold -
C’ GFP library on the background of CCT mutant

below threshold17.77311.07159No
Click here to export images as ZIP file
Warning! Downloading images of search results that contain many genes may take some time. Please be patient.
Warning! Downloading images of search results that contain many genes may take some time. Please be patient.
